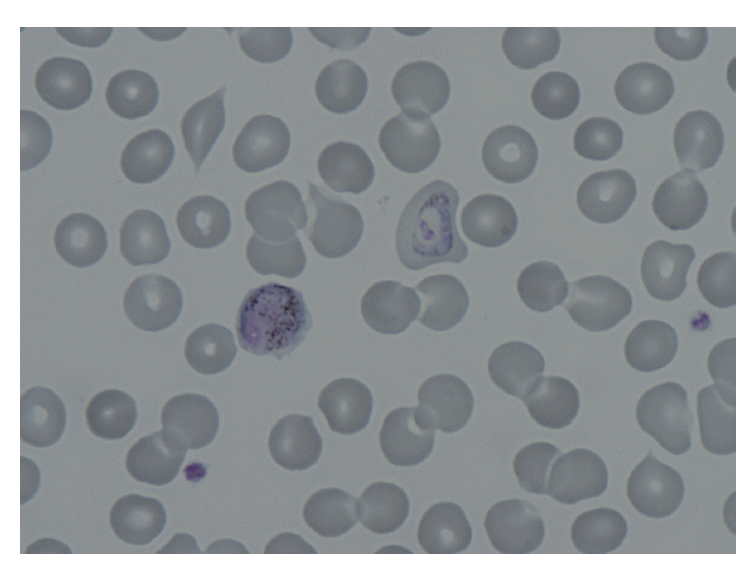
0

Abstract
An enlarged spleen is considered one of the most common signs of malaria, and splenic rupture rarely occurs as an important life-threatening complication. Splenectomy has been recommended as the treatment of choice for hemodynamically unstable patients. However, a very limited number of splenic rupture patients have been treated with transcatheter coil embolization. Here we report a 38-year-old Korean vivax malaria patient with ruptured spleen who was treated successfully by embolization of the splenic artery. The present study showed that angiographic embolization of the splenic artery may be an appropriate option to avoid perioperative harmful effects of splenectomy in malaria patients.
-
Key words: Plasmodium vivax, malaria, spleen, spontaneous rupture, coil embolization
INTRODUCTION
Malaria is a serious, mosquito-borne, infectious disease that is caused by
Plasmodium species. Among these species,
Plasmodium vivax is the most common human malaria parasite and endemic in many regions of Asia, the South Pacific, North Africa, the Middle East, and South and Central America [
1].
Malaria can present with various signs and complications on computed tomography (CT) including splenomegaly, hepatomegaly, focal low attenuation in the spleen, gallbladder wall edema, periportal edema, ascites and splenic rupture, or hemorrhage [
2]. While an enlarged spleen is considered one of the most common signs, splenic rupture rarely occurs as an important life-threatening complication. Therefore, early diagnosis and appropriate disease management are essential.
No well-established studies on the management of the splenic rupture in malaria patients have been performed. Traditionally, non-operative conservative management was performed for the hemodynamically stable patients. However, for the persistently hemodynamically unstable patients, splenectomy has been recommended as a treatment of choice. To the best of our knowledge, a very limited number of malarial splenic rupture patients have been treated with transcatheter coil embolization. However, splenic preservation is more strongly recommended if possible due to the important role of the spleen in immunity. Here we report a Korean P. vivax malaria patient with a spontaneous splenic rupture that was successfully managed by embolization of the splenic artery.
CASE RECORD
A 38-year-old South Korean male visited the Emergency Department of Inha University Hospital with a sudden onset of severe abdominal pain and vomiting. He had suffered from intermittent fever during the previous 10 days. His pulse rate was 132 beats per min and his respiratory rate was 22 per min. The patient also had hypotension (95/63 mmHg) as well as high fever (39˚C). He had undergone chemotherapy and radiation therapy for orbital marginal zone B-cell lymphoma in October 2010 and 2011 as well as an anterior orbitotomy and mass excision thereafter. One day before visiting the Emergency Department, he underwent an orbital CT and blood test. No abnormal CT findings or blood test results were obtained. In addition, recurrence of the orbital tumor was not observed.
Given the characteristic intermittent fever, a peripheral blood smear and rapid blood assay for malaria were conducted. Based on the results, the patient was diagnosed with
P. vivax (
Fig. 1). A prompt examination with an abdominal CT revealed that the patient suffered from hemoperitoneum (36 HU on portal phase). The spleen was enlarged and surrounded by a high attenuated fluid collection (61 HU on portal phase;
Fig. 2). The surface of the spleen was scalloped due to the fluid accumulation. Higher attenuation of the perisplenic fluid compared to the other site of hemoperitoneum and splenomegaly led to a diagnosis of spontaneous splenic rupture resulting in a subcapsular hematoma.
The patient’s hemoglobin level was 14.4 g/dl 1 day before visiting the Emergency Department and decreased to 11.0 g/dl. The concentration then rapidly dropped to 9.5 g/dl, and the patient received a blood transfusion. The patient also had thrombocytopenia (71 k/μl) with 33 IU/L AST, 44 IU/L ALT, 25.4 mg/dl BUN, and 1.66 mg/dl creatinine. He was admitted to the intensive care unit for a conservative treatment. Despite transfusion, the hemoglobin levels and blood pressure remained unstable. On the second day of hospitalization, a splenic angiogram was performed. No definitive extravasation of contrast media was observed, but contour irregularity was noted in the lateral lower margin (
Fig. 3). Embolization was performed with 7 coils (10×4 mm, 8×4 mm, 6×2 mm; Cook, Bloomington, Minneapolis, USA) at the distal splenic artery level (
Fig. 4).
A follow-up CT was performed 5 days after the coil embolization. At this time, a reduced splenic subcapsular hematoma was observed. Several peripheral wedge-shaped low attenuated lesions were also found in the spleen, suggesting splenic infarction resulting from the coil embolization (
Fig. 5). Hemoglobin levels were normalized (13.9 g/dl). After discharge, the patient has been closely followed-up at the Outpatient Department of Inha University Hospital. No other complications have developed.
DISCUSSION
Malaria is a parasitic disease that occurs in over 100 tropical and subtropical countries. Splenomegaly is one of the most common clinical features of malaria, and is estimated to occur in 70-80% of acute cases [
3]. A previous review of 22 cases demonstrated that marked splenic enlargement and rupture are most commonly caused by
P. vivax among the
Plasmodium species [
4]. There is no difference in clinical presentations according to infection by
Plasmodium species [
5].
The pathophysiology of splenic rupture in malaria patients is unclear. However, 3 mechanisms have been suggested [
4,
6]. First, increased intrasplenic tension caused by cellular hyperplasia and engorgement may result in splenic rupture. Second, the spleen may be compressed by the abdominal musculature during physical activities. Finally, vascular occlusion due to reticuloendothelial hyperplasia may develop, resulting in thrombosis and infarction. This leads to interstitial and subcapsular hemorrhage along with stripping of the capsule, thus leading to further subcapsular hemorrhage.
No well-established studies on the management of the splenic rupture in malaria patients have been performed. Currently, splenectomy has been accepted as the traditional treatment of choice in most cases of splenic rupture. However, perioperative risks associated with splenectomy and growing concerns about the loss of immunologic functions have promoted the development of nonsurgical management strategies [
7,
8]. These techniques include careful observation in the hospital, strict bed rest, and maintenance of hemodynamics as well as hemoglobin levels with blood and blood products [
9]. Hemodynamic instability despite resuscitation efforts indicates nonsurgical management failure.
Osman et al. [
8] formulated a flowchart for the management of malarial splenic rupture after reviewing 252 cases previously reported in the literature. This group emphasized the importance of non-operative management of hemodynamically stable patients but recommended splenectomy as a treatment for persistent hemodynamic instability. Angiography with embolization may also be a potential therapy. However, angiographic embolization was omitted from the flowchart because this modality may not be available as a salvage therapy in many clinical settings.
To the best of our knowledge, a very limited number of malarial splenic rupture patients have been treated with transcatheter coil embolization [
10]. However, splenic artery embolization has been reported to have a high success rate in trauma patients and preferable to splenectomy [
11,
12]. Despite the associated risks such as radiation exposure and more time-consuming, or technically challenging, angiographic embolization may be an appropriate option for avoiding harmful effects of splenectomy for malaria patients.
Notes
-
We have no conflict of interest related to this work.
This paper was supported by INHA University Research Fund (2014).
Fig. 1.Peripheral blood smear showing a trophozoite and a macrogametocyte of Plasmodium vivax in this patient (Wright-Giemsa stain, × 1,000).

Fig. 2.Initial CT performed at the emergency department revealed the presence of hemoperitoneum and a perisplenic hematoma.

Fig. 3.No definitive extravasation of contrast media was viewed on the splenic angiogram, but contour irregularity was noted in the lateral lower margin.

Fig. 4.Embolization was performed with 7 coils at the distal splenic artery level.

Fig. 5.Follow-up CT was performed 5 days after the coil embolization. The extent of the splenic subcapsular hematoma was decreased and splenic infarction developed.

References
- 1. Echeverri M, Tobón A, Alvarez G, Carmona J, Blair S. Clinical and laboratory findings of Plasmodium vivax malaria in Colombia, 2001. Rev Inst Med Trop Sao Paulo 2003;45:29-34.
- 2. Kim EM, Cho HJ, Cho CR, Kwak YG, Kim MY, Cho YK. Abdominal computed tomography findings of malaria infection with Plasmodium vivax. Am J Trop Med Hyg 2010;83:1202-1205.
- 3. Neva FA, Sheagren JN, Shulman NR, Canfield CJ. Malaria: host-defense mechanisms and complications. Ann Intern Med 1970;73:295-306.
- 4. Patel MI. Spontaneous rupture of a malarial spleen. Med J Aust 1993;159:836-837.
- 5. Imbert P, Rapp C, Buffet PA. Pathological rupture of the spleen in malaria: analysis of 55 cases (1958–2008). Travel Med Infect Dis 2009;7:147-159.
- 6. Tauro LF, Maroli R, D'Souza CR, Hegde BR, Shetty SR, Shenoy D. Spontaneous rupture of the malarial spleen. Saudi J Gastroenterol 2007;13:163-167.
- 7. Shaw JHF, Print CG. Postsplenectomy sepsis. Br J Surg 1989;76:1074-1081.
- 8. Osman MF, Elkhidir IM, Rogers SO Jr, Wiliams M. Non-operative management of malarial splenic rupture: the Khartoum experience and an international review. Int J Surg 2012;10:410-414.
- 9. Mokashi AJ, Shirahatti RG, Prabhu SK, Vagholkar KR. Pathological rupture of malarial spleen. J Postgrad Med 1992;38:141-142.
- 10. Ribordy V, Schaller MD, Martinet O, Doenz F, Liaudet L. Spontaneous rupture of the spleen during malaria treated with transcatheter coil embolization of the splenic artery. Intensive Care Med 2002;28:996.
- 11. Bessoud B, Denys A, Calmes JM, Madoff D, Qanadli S, Schnyder P, Doenz F. Nonoperative management of traumatic splenic injuries: is there a role for proximal splenic artery embolization? AJR Am J Roentgenol 2006;186:779-785.
- 12. Raikhlin A, Baerlocher MO, Asch MR, Myers A. Imaging and transcatheter arterial embolization for traumatic splenic injuries: review of the literature. Can J Surg 2008;51:464-472.
Citations
Citations to this article as recorded by